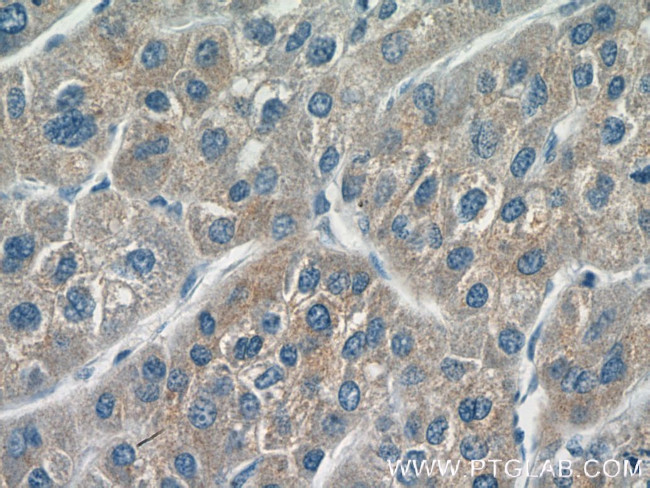
CYP20A1 Antibody in Immunohistochemistry (Paraffin) (IHC (P))

Search
Proteintech
CYP20A1 Polyclonal Antibody
{{$productOrderCtrl.translations['antibody.pdp.commerceCard.promotion.promotions']}}
{{$productOrderCtrl.translations['antibody.pdp.commerceCard.promotion.viewpromo']}}
{{$productOrderCtrl.translations['antibody.pdp.commerceCard.promotion.promocode']}}: {{promo.promoCode}} {{promo.promoTitle}} {{promo.promoDescription}}. {{$productOrderCtrl.translations['antibody.pdp.commerceCard.promotion.learnmore']}}
产品信息
16702-1-AP
种属反应
宿主/亚型
分类
类型
抗原
偶联物
形式
浓度
规格
纯化类型
保存液
内含物
保存条件
运输条件
产品详细信息
Immunogen sequence: SGGGSVSEN HMREKLYENG VTDSLKSNFA LLLKLSEELL DKWLSYPETQ HVPLSQHMLG FAMKSVTQMV MGSTFEDDQE VIRFQKNHGT VWSEIGKGFL DGSLDKNMTR KKQYEDALMQ LESVLRNIIK ERKGRNFSQH IFIDSLVQGN LNDQQILEDS MIFSLASCII TAKLCTWAIC FLTTSEEVQK KLYEEINQVF GNGPVTPEKI EQLRYCQHVL CETVRTAKLT PVSAQFQDIE GKIDRFIIPR ETLVLYALGV VLQDPNTWPS PHKFDPDRFD DELVMKTFSS LGFSGTQECP ELRFAYMVTT VLLSVLVKRL HLLSVEGQVI ETKYELVTSS REEAWITVSK RY (112-462 aa encoded by BC020616)
靶标信息
CYP20A1 is a member of the cytochrome P450 superfamily of enzymes. The cytochrome P450 proteins are monooxygenases that catalyze many reactions involved in drug metabolism and synthesis of cholesterol, steroids and other lipids. The protein lacks one amino acid of the conserved heme binding site. It also lacks the conserved I-helix motif AGX(D, E)T, suggesting that its substrate may carry its own oxygen.
仅用于科研。不用于诊断过程。未经明确授权不得转售。
篇参考文献 (0)
生物信息学
蛋白别名: CYP-M; Cytochrome P450 20A1; cytochrome P450 monooxygenase; cytochrome P450, 20a1; cytochrome P450, family 20, subfamily A, polypeptide 1; unnamed protein product
基因别名: A930011N14Rik; CYP-M; CYP20A1; Cypm; UNQ667/PRO1301
UniProt ID: (Human) Q6UW02, (Mouse) Q8BKE6, (Rat) Q6P7D4
Entrez Gene ID: (Human) 57404, (Mouse) 77951, (Rat) 316435